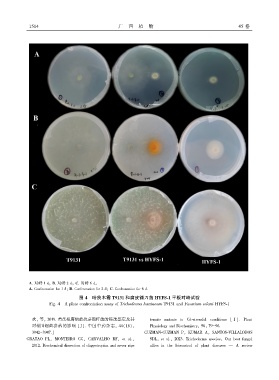

Page 148 - 《广西植物》2025年第8期
P. 148
1 5 1 4 广 西 植 物 45 卷
A. 对峙 1 dꎻ B. 对峙 2 dꎻ C. 对峙 6 dꎮ
A. Confrontation for 1 dꎻ B. Confrontation for 2 dꎻ C. Confrontation for 6 d.
图 4 哈茨木霉 T9131 和腐皮镰刀菌 HYFS ̄1 平板对峙试验
Fig. 4 A plate confrontation assay of Trichoderma harzianum T9131 and Fusarium solani HYFS ̄1
欢ꎬ 等ꎬ 2019. 黄芪根腐病拮抗芽孢杆菌的筛选鉴定及其 tomato mutants to Cd ̄stressful conditions [ J ]. Plant
对根围细菌群落的影响 [J]. 中国中药杂志ꎬ 44(18): Physiology and Biochemistryꎬ 56: 79-96.
3942-3947.] GUZMAN ̄GUZMAN Pꎬ KUMAR Aꎬ SANTOS ̄VILLALOBOS
GRATAO PLꎬ MONTEIRO CCꎬ CARVALHO RFꎬ et al.ꎬ SDLꎬ et al.ꎬ 2023. Trichoderma species: Our best fungal
2012. Biochemical dissection of diageotropica and never ripe allies in the biocontrol of plant diseases — A review